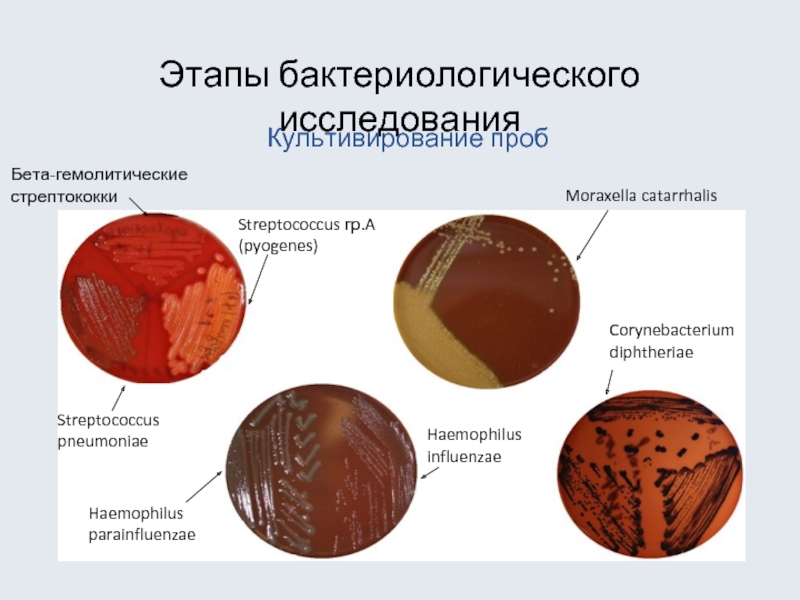

- Главная
- Разное
- Дизайн
- Бизнес и предпринимательство
- Аналитика
- Образование
- Развлечения
- Красота и здоровье
- Финансы
- Государство
- Путешествия
- Спорт
- Недвижимость
- Армия
- Графика
- Культурология
- Еда и кулинария
- Лингвистика
- Английский язык
- Астрономия
- Алгебра
- Биология
- География
- Детские презентации
- Информатика
- История
- Литература
- Маркетинг
- Математика
- Медицина
- Менеджмент
- Музыка
- МХК
- Немецкий язык
- ОБЖ
- Обществознание
- Окружающий мир
- Педагогика
- Русский язык
- Технология
- Физика
- Философия
- Химия
- Шаблоны, картинки для презентаций
- Экология
- Экономика
- Юриспруденция
Микробиологическая диагностика инфекционно-воспалительных процессов дыхательных путей и ЛОР органов презентация
Содержание
- 1. Микробиологическая диагностика инфекционно-воспалительных процессов дыхательных путей и ЛОР органов
- 2. Классификация заболеваний ВДП, НДП и ЛОР органов
- 3. Классификация заболеваний ВДП, НДП и ЛОР органов
- 4. Этиологически значимые микроорганизмы – возбудители инфекций ВДП
- 5. Этиологически значимые микроорганизмы – возбудители инфекций ВДП
- 6. Этиологически значимые микроорганизмы – возбудители инфекций ЛОР-органов
- 7. Этиологически значимые микроорганизмы – возбудители инфекций ЛОР-органов
- 8. Этиологически значимые микроорганизмы – возбудители инфекций НДП
- 9. Этиологически значимые микроорганизмы – возбудители инфекций НДП
- 10. Этиологически значимые микроорганизмы – возбудители инфекций НДП
- 11. Этиологически значимые микроорганизмы – возбудители инфекций НДП
- 12. Этапы микробиологического исследования Получение проб биоматериала (носоглоточные
- 13. Процедура взятия биоматериала Взятие мазка из зева Взятие мазка из носовой полости
- 14. Бактериоскопическое исследование C.diphtheriae окраска по Леффлеру C.diphtheriae
- 15. Этапы бактериологического исследования Культивирование проб Streptococcus pneumoniae
- 16. Этапы микробиологического исследования
- 17. Этапы микробиологического исследования Определение чувствительности к антибиотикам для клинически значимых культур
- 18. Интерпретация результатов Для специфических инфекций (дифтерия, коклюш, менингит) – в норме результат отрицательный
- 19. Интерпретация результатов (продолжение) *Микробиологический справочник для клиницистов
- 20. Преаналитические требования (общие) Биоматериал целесообразно получать до
- 21. Преаналитические требования по видам биоматериала Материал
- 22. Преаналитические требования по видам биоматериала Материал
- 23. Основные цели лечения при инфекциях ЛОР-органов,
- 24. Стандарты антибактериальной терапии Эрадикация основная цель антибиотикотерапии
- 25. Стандарты антибактериальной терапии Эрадикация возбудителей
Слайд 1Микробиологическая диагностика инфекционно-воспалительных процессов дыхательных путей и ЛОР органов
Слайд 2Классификация заболеваний ВДП, НДП и ЛОР органов
Специфические инфекции – дифтерия, коклюш,
Corynebacterium diphtheriae
Bordetella pertussis
Neisseria meningitidis
Слайд 3Классификация заболеваний ВДП, НДП и ЛОР органов
Неспецифические инфекции – отит, риносинусит,
Слайд 4Этиологически значимые микроорганизмы – возбудители инфекций ВДП
Эпиглоттит
Бактерии
Haemophilus influenzae
Streptococcus pneumoniae
Staphylococcus aureus
Тонзиллофарингит
Бактерии
Streptococcus гр.A
Streptococcus гр.C
Archanobacterium haemolyticum
Chlamydia pneumoniae
Neisseria gonorrhoeae
Mycoplasma pneumoniae
Вирусы - 70% в общей структуре возбудителей
Слайд 5Этиологически значимые микроорганизмы – возбудители инфекций ВДП (продолжение)
Бактерии
Streptococcus pneumoniae - 46%
Haemophilus
Staphylococcus aureus
Moraxella catarrhalis - 4%
Streptococcus гр.A (pyogenes)
Chlamydia pneumoniae
Pseudomonas aeruginosa
Анаэробы - 4-11%
Риносинусит
Вирусы
Грибы
Aspergillus (аллергический синусит)
Hyphomycetes (аллергический синусит)
Zygomycetes
Слайд 6Этиологически значимые микроорганизмы – возбудители инфекций ЛОР-органов
Наружный отит
Грибы
Aspergillus spp.
Candida albicans
Бактерии
Pseudomonas aeruginosa
Staphylococcus
Streptococcus гр.A (pyogenes)
Слайд 7Этиологически значимые микроорганизмы – возбудители инфекций ЛОР-органов (продолжение)
Средний отит
Бактерии
Streptococcus pneumoniae –
Haemophilus influenzae - 10%
Moraxella catarrhalis - 10%
Staphylococcus aureus - 5%
Streptococcus гр.A (pyogenes) - 10%
Анаэробы - 5%
Вирусы
Слайд 8Этиологически значимые микроорганизмы – возбудители инфекций НДП
Бактерии
Haemophilus influenzae - 43%
Streptococcus pneumoniae
Moraxella catarrhalis - 17%
Mycoplasma pneumoniae - 5%
Chlamydia pneumoniae – 5%
Вирусы
Бронхит
Слайд 9Этиологически значимые микроорганизмы – возбудители инфекций НДП (продолжение)
Бактерии
Staphylococcus aureus
Streptococcus pneumoniae
Streptococcus гр.A
Bacteroides fragilis
Klebsiella pneumoniae (и др.грамотриц.п-ки)
Actinomyces spp.
Mycobacterium tuberculosis
Эмпиема
Грибы
Aspergillus spp.
Pneumocystis carinii
Простейшие
Entamoeba histolytica
Слайд 10Этиологически значимые микроорганизмы – возбудители инфекций НДП (продолжение)
Пневмония
Бактерии
Streptococcus pneumoniae -
Staphylococcus aureus – 10%
Haemophilus influenzae - 10%
Другие – 20%:
Mycoplasma pneumoniae
Chlamydia (C.trachomatis, C. pneumoniae, C.psittaci)
Klebsiella pneumoniae (и др.Enterobacteriaceae)
Pseudomonas aeruginosa
Burholderia pseudomallei
Legionella pneumophila
Francisella tularensis
Bacteroides fragilis
Nocardia spp.
Слайд 11Этиологически значимые микроорганизмы – возбудители инфекций НДП (продолжение)
Пневмония
Вирусы
Грибы
Pneumocystis carinii
Cryptococcus neuformans
Histoplasma capsulatum
Blastomyces
Coccidioides brasiliensis
Aspergillus spp.
Phycomyces spp.
Простейшие и паразиты
Ascaris lumbricoides
Srtongyloides stercoralis
Toxoplasma gondii
Слайд 12Этапы микробиологического исследования
Получение проб биоматериала (носоглоточные мазки, аспират из пазух, мазки
Слайд 14Бактериоскопическое исследование
C.diphtheriae окраска по Леффлеру
C.diphtheriae окраска по Нейссеру
S. pneumoniae в гное.
N/ meningitidis в гное. Окраска по Граму. Внутриклеточное расположение диплококков
Слайд 15Этапы бактериологического исследования
Культивирование проб
Streptococcus pneumoniae
Streptococcus гр.A (pyogenes)
Бета-гемолитические стрептококки
Haemophilus influenzae
Moraxella catarrhalis
Corynebacterium
Haemophilus parainfluenzae
Слайд 17Этапы микробиологического исследования
Определение чувствительности к антибиотикам для клинически значимых культур
Слайд 18Интерпретация результатов
Для специфических инфекций (дифтерия, коклюш, менингит) – в норме результат
Слайд 19Интерпретация результатов (продолжение)
*Микробиологический справочник для клиницистов Дж.Х.Йоргенсен, М.А.Пфаллер 2006)
Для неспецифических инфекций
Полость носа
«Зеленящие» стрептококки
Коагулазоотрицательные стафилококки
Neisseria spp.
Haemophilus spp.
Полость рта и ротоглотки
«Зеленящие» стрептококки
Коагулазоотрицательные стафилококки
Corynebacterium spp.
Micrococcus spp.
Neisseria spp.
Haemophilus spp.
Stomatococcus spp.
Peptostreptococcus spp.
Fusobacterium spp.
Porphyromonas spp.
Prevotella spp.
Veillonella spp.
Actinomyces spp.
Eubacterium spp.
Propionibacterium spp.
Candida spp.
Наружное ухо
Коагулазоотрицательные стафилококки
Corynebacterium spp.
Propionibacterium spp.
Слайд 20Преаналитические требования
(общие)
Биоматериал целесообразно получать до начала антимикробной терапии
Материал берут непосредственно из
Соблюдение асептики, избегая контаминации посторонней микрофлорой
Количество материала должно быть достаточным для проведения исследования
Сроки и температурный режим при доставке должны соответствовать виду биоматериала, цели исследования
Сопроводительные документы (бланки направлений) должны быть оформлены максимально информативно в соответствии с пунктами
Слайд 21Преаналитические требования по видам биоматериала
Материал при инфекциях ВДП
Берут натощак или
Не рекомендуется исследовать промывную жидкость и мазки из носоглотки, т.к. образцы контаминируются нормальной микрофлорой ВДП
Содержимое аспирационного шприца после пункции верхнечелюстной пазухи переносят на стерильный тампон и затем в среду Эймс с углем
Вводят тампон в носовой ход до упора на уровне носовой раковины (около 2,5 см) и вращательными движениями собирают материал со слизистой носа, повторяют процедуру в другом носовом ходе этим же тампоном. Тампон погрузить в среду Эймс с углем
Очищают наружный слуховой проход слабым раствором антисептика, после прокола барабанной перепонки врач шприцем набирает жидкость и далее переносит ее на стерильный тампон, входящий в состав транспортной среды Эймс с углем. При прободении барабанной перепонки экссудат собирают стерильным тампоном, входящим в состав транспортной среды Эймс с углем и затем помещают в пробирку со средой
Обрабатывают кожу 70% этиловым спиртом и промывают стерильным изотоническим раствором (физраствором)
Материал из очага берут стерильным тампоном , входящим в состав транспортной среды Эймс с углем и затем помещают в пробирку со средой
Образцы из стенки глотки
Мазки из носа
Аспират из носовых пазух
Материал при воспалении наружного уха
Жидкость при тимпаноцентезе
Слайд 22Преаналитические требования по видам биоматериала
Материал при инфекциях НДП
Исследуют утреннюю порцию
Мокрота
Специальным шприцем в трахею вводят около 10 мл стерильного физраствора и собирают откашливаемый смыв в стерильную посуду. Бронхиальные смывы могут быть сделаны с помощью бронхоскопа. Смывную жидкость помещают в стерильный контейнер с крышкой, которую плотно завинчивают
Трахеобронхиальные смывы
Кожу перед пункцией обрабатывают 2% раствором йода, а затем 70% этиловым спиртом. После прокола жидкость собирают шприцем в стерильную пробирку и незамедлительно отправляют в лабораторию
Плевральная жидкость
Слайд 23
Основные цели лечения при инфекциях ЛОР-органов, ВДП и НДП
Эффективное лечение
Снижение длительности
Эрадикация возбудителя
Предупреждение развития
осложнений
Слайд 24Стандарты антибактериальной терапии
Эрадикация
основная цель антибиотикотерапии инфекций респираторного тракта и ЛОР-органов
Активность антибиотика
Достаточные концентрации антибиотика в очаге инфекции
Поддержание подавляющих рост бактерий концентраций в течение необходимого времени
Слайд 25Стандарты антибактериальной терапии
Эрадикация возбудителей инфекций респираторного тракта позволяет разорвать порочный
Острое течение
ОБОСТРЕНИЕ
Неадекватный
антибиотик
Персистенция бактерий
Селекция
резистентности
Отсутствие
эрадикации
Адекватный
антибиотик
Эрадикация
ВЫЗДОРОВЛЕНИЕ
Увеличение безрецидивного
интервала